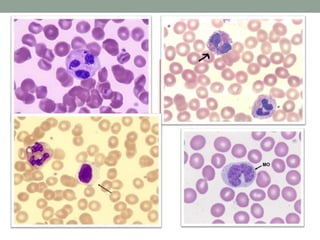

O documento descreve os principais constituintes do sangue humano, incluindo o plasma, glóbulos vermelhos, glóbulos brancos e plaquetas. Discutem-se as funções do sangue no transporte de gases, nutrientes e produtos de excreção, defesa do organismo e manutenção do equilíbrio interno. Detalha-se que os glóbulos vermelhos transportam oxigênio através da hemoglobina, enquanto os glóbulos brancos fornecem defesa e as plaquetas auxiliam na coagulação